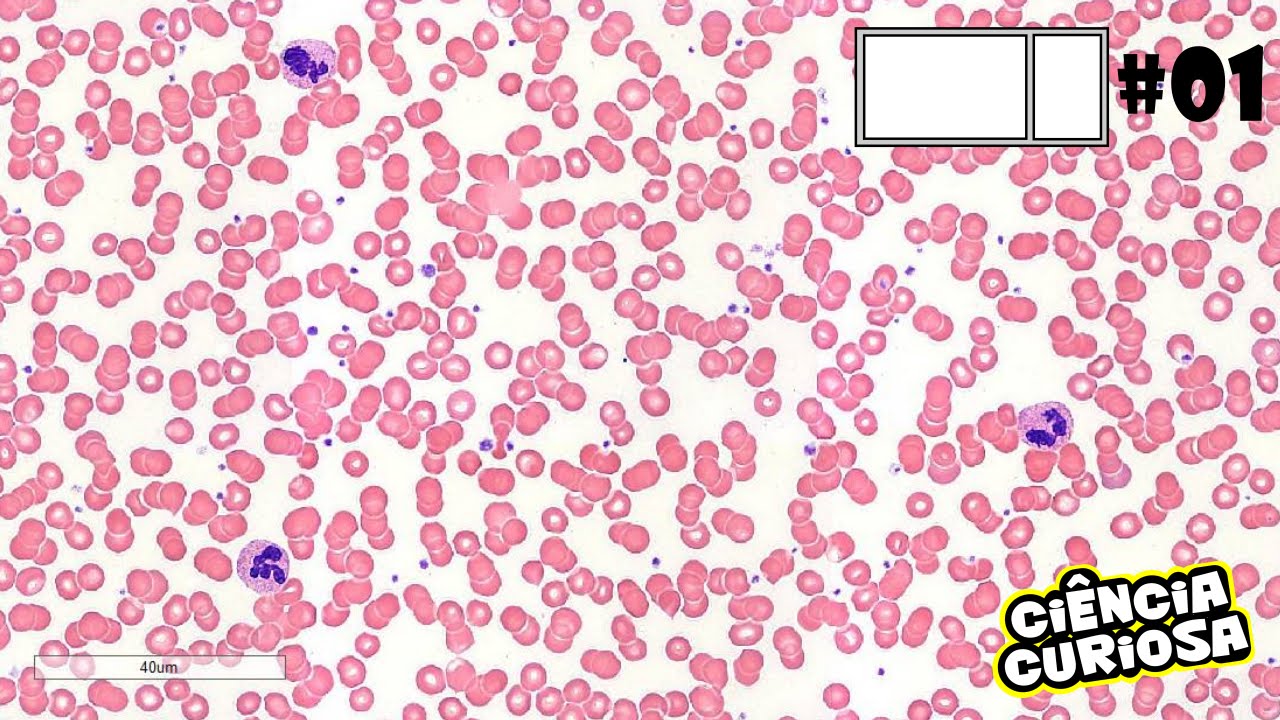
Microscopia Células do Sangue (IS #01)

Oi e aí pessoal do facilitando A Medicina tudo bom com vocês eu sou Cleverson do woofer que a gente vai para mais uma aula referente à Hematologia essa playlist que estão fazendo só sobre o estudo do sangue então se eu te ajudar de alguma forma você quiser receber mais conteúdos mais vídeo aulas E participar aqui da nossa comunidade no YouTube se inscreve no canal galera esse botãozinho vermelhinho que fica embaixo do vídeo deixa eu já ia e vão te interessa galera hoje como você já deve ter visto no Título nós vamos falar sobre os componentes
do sangue ou as células sanguíneas mas antes vamos ver algumas características sobre essa sangue a sua composição Então esse sangue galera ele vai estar sempre percorrendo na sua naturalidade a um componente ou sistema fechado que seria o sistema o relatório agora ele vai percorrer por esse sistema circulatório dentro de artérias de veias capilares e a sua principal direção vai ser unidirecional ou seja sempre seguindo o mesmo caminho e ele possui uma bomba se você já deve ter ouvido falar que é o coração então lembre-se normal ele está dentro de um compartimento fechado Claro se ocorrer
uma lesão de um vaso vai estravazar nesse sangue mas o normal é dentro dos vasos sanguíneos tem a bomba que o coração e sempre na mesma direção ele irá seguir agora a gente tem que destacar suas funções o das funções é levar nutrientes sem função de transporte ou seja aqueles nutrientes que a gente se alimentou foi absorvido no nosso intestino mais ser transportado pelo sangue para os diversos e recibos e diversas células do nosso corpo lembrando também que ele tem uma função primordial galera na no transporte também de metabólitos descrição ou seja aquilo que a
célula já não vai utilizar vai ser transportado pelo nosso sangue para depois ser eliminado outra função seria o transporte de gases Como o oxigênio o céu dois oxigênio também né do da hematose ali no nossos pulmões vai ser levado para as células e aliás ela realizar o seu metabolismo outra função ele mais tarde certa forma levando células de defesa Como os leucócitos que a gente vai falar mais à frente e também possui as plaquetas que tem a função de reparo dos vasos quando ocorrer alguma lesão algum sangramento Beleza outro. Ele tem uma função de regulação
Ass é também uma regulação da temperatura e uma função na regulação osmótica no nosso corpo Então galera a gente já sabe que o sangue está ali um compartimento fechado sempre seguindo uma direção e também o coração é a principal bombas sabemos as suas funções agora na sua composição o que a gente pode fazer olha na imagem galera quando a gente vai fazer um exame no paciente por exemplo a gente ir o sangue dEle se a gente colocar ali no tubo de ensaio a gente centrifugar esse sangue ou deixar ele de cantar a gente vai ver
exatamente dessa forma hoje a olho nu a gente vê a parte de baixo avermelhadas e essa parte Vermelha em principal seria os nossos eritrócitos os glóbulos vermelhos como você preferir mais acima nós temos os leucócitos ter ele hummm hummm mais esbranquiçados beleza mas assim umas carinhas plaquetas claro que a gente não enxergar porque são fragmentos muito pequenos mas lembre-se que está um pouco acima do seu corpos e essa montanha acima aí seria as plaquetas essas ou melhor as plaquetas não o plasma o plasma que tem um tom assim New amarelado para transparente se você gente
pode dizer que nada mais seria do que a parte liquida do nosso sangue Beleza então lembre-se a gente tem essa parte avermelhada e massas essa parte branca sobre os linfócitos os nossos nossas células de defesa os opostos a gente vai falar mais à frente e ainda nós temos o plasma esse plasma que tirei a parte liquida do sangue e a gente falou do plasma o que a gente pode falar a gente já sabe que é a parte líquida que é uma grande quantidade Olha só ir né Agora ele só líquido é suave outro ele não
galera existem muitas proteínas como a albumina é importante proteína que vai atuar em transporte de alguns substâncias por esse sangue também lipoproteínas também proteínas relacionadas a coagulação como pró-trombina fibrinogênio em sim tem várias proteínas ali mas é só proteína que tem não nós temos sais inorgânicos os sais que vão ser utilizados no nosso corpo mas também substâncias orgânicas como vitaminas e também a glicose que é a nossa principal fonte energética para o nosso corpo Então galera a gente já viu várias características desse sangue e já vemos com a sua composição agora vamos falar das células
que compõem esse sangue que é o o que começando com a e masha os nossos glóbulos vermelhos que a gente tem que saber sobre masha primeiro era uma célula e será anucleada portanto ela não tem núcleo ela tem um formato meio diferente como a gente vê nessa imagem ela meio é puxada para dentro você sempre pode dizer que a gente chama isso de biconcavo isso é importantíssimo para essa célula que possui só 7.5 micrômetros como a gente veio aqui que essa importância dela ser pequena e bicôncava EA nuclear é exatamente essa flexibilidade que ela vai
ter o que essa flexibilidade é importante Principalmente quando ela passar por capilares muito pequenos onde ela consegue certa deformidade para passar por esses locais muito estreitos não lembro ela é sem núcleo e é o bico que facilita essa flexibilidade dessa célula Outro ponto ela possui a hemoglobina dentro dela essa hemoglobina que estaria associada o ferro e estaria Transportando o famoso oxigênio para as nossas células Então lembre-se dentro dessa massa tem hemoglobina conjugada com ferro para transportar o oxigênio Lembrando que a principal fonte de energia dessas células seria ver quase e ela tem uma duração no
nosso corpo de cerca de 120 dias se não houver nenhum outro problema então 120 dias é o tempo de duração de vida você sempre pode dizer deve ser Márcia e ela vai ser destruída lá no baixo quando os macrófagos quando ela tiver velhinha ou já com algum problema já desgastada ela passa pelo baixo lá no baixo os macrófagos irão fagocitar E aí destrói E essas é marchas velhas ou danificadas são galera Essas são as principais características das hemácias um pouco que a gente não pode esquecer são os reticulócitos os reticulócitos galera eu quero que você
grave aí nada mais são do que hemácias ou glóbulos vermelhos que ainda estão imaturos agora eles são também produzidos ali na medula óssea e o normal é que tenha tem que isso umas quantidades de reticulócitos no nosso sangue baixíssimo mesmo bem pouquinho se eu tenho grandes quantidades de reticulócitos ali no nosso sangue e se indica que existe algum problema algo patológico ou alguma stress que tá acontecendo nem sim divido Porque pensa só quando liberam muitos reticulócitos é porque eu tô sem masha ou seja tá faltando é Márcia a medo Nossa vai acabar liberando essas células
imaturas B o início eu só quero que você guarde isso a gente vai aprofundar isso mais à frente agora outro ponto é que a lista acaba diferenciando uma hemácia normal de um reticulócito é que ela não pense formato ali completamente bicôncavo e possui ribossomos dentro dele como a gente mesmo essa imagem vários pontinhos ali e característica a presença desse robô sol bela a gente já falou das hemácias os reticulócitos que são é massas e matures e os leucócitos galera os leucócitos eles são produzidos também na medula óssea mas também nos órgãos linfoides eles são temporários
no sangue ele só atuou em um momento que eu necessito de ação de defesa no nosso corpo é ou seja eles sofrem a diapedese eles migram para os tecidos-alvo onde está tendo algum problema para eles combater esses agentes o vírus bactérias etc Beleza então eu posso só agem ou seja estão presentes no sangue quando tem algum probleminha tranquilo são produzidos na medula óssea e também em órgãos linfoides a gente pode dirigir destacar e diferenciar esses linfócitos são classificados em agranulócitos e granulócitos os granulócitos galera seriam neutrófilos eosinófilos e os basófilos já quando a gente fala
dos agranulócitos seriam linfócitos e monócitos vamos falar primeiro sobre os granulócitos começando com o neutrófilo o meu troco galera é uma célula arredondada seria grande e ela é segmentada a construir ele alguns Logos que a gente vê aqui nessa imagem esses esses neutrófilos possui até 5 Logos o possui os gregos principalmente grânulos azurófilos e específicos a principal função dessa célula galera seria na fagocitose e Destruição além das bactérias e também de alguns agentes invasores e não são desejáveis nesse organismo então eles vão fagocitar e destruir bactérias outro leucócito que é granulócitos eosinófilos esse osinox também
é ali arredondado possui um núcleo bilobulado seja parece dois núcleos ali bilobulado ele também tem além desse aspecto bilobulado a gente tem que lembrar que ele possui grânulos acidófilos agora qual a função de seus dinossauros o em Tem uma função galera principalmente contra parasitas com o museu metros a Lady antivirais e além desses antivirais E aí vai atuar em reações que tem ali uma ação alérgica e uma reação alérgica outro que a gente pode citar seria os basófilos esses basófilos possui um núcleo grande realmente Grande ele tem Principalmente uma ação galera contra é geralmente libera
histamina e tem ação e principalmente Alerta já que a 6 família tem ação principalmente em reações alérgicas lembrando também galera que outra característica desse basofilo é que ele possui grânulos metacromáticos além desse lucro que a gente falou que ele é ali e-mail o joelho EA função que a gente já citou stamina reação alérgica principalmente nessas reações alérgicas e tem uma ação também relacionada aos linfócitos B então basicamente esses seriam os leucócitos granulócitos neutrófilos eosinófilos e basófilos vamos falar agora dos agranulócitos quando a gente fala dos leucócitos agranulócitos nós falamos dos monócitos e os impostos os
monócitos galera seriam essas células grandes realmente talvez aí a as maiores que a gente pode citar esses monócitos que possui um núcleo excêntrico ou seja não está o centro e possui função principalmente de apresentar antígenos aos linfócitos e também quando eles me ligam para os tecidos ele se diferenciam em uma tropos e galera esses macrófagos que são formados nesses tecidos tem a função exatamente de fagocitar e destruir as células umas horas células estranhas a esse corpo outro tipo de leucócitos agranulócitos nós podemos destacar os linfócitos esses linfócitos é certa forma possui uma forma esférica um
núcleo esférico e sua função estaria relacionada aos tipos desses linfócitos que a gente pode destacar em três primeiro a gente teria o linfócito B que vai ter uma diferenciação quando estiver Maduro e vai ter uma função de produção de anticorpos não temos ainda o linfócito t que tem função de destruir células danificadas e Células invasoras E ainda a gente pode enquadrar nesse grupo dos impostos as famosas células NK que tem uma função de combater e destruir células que são tumorais células anómalas em nosso organismo Então galera a gente falou das hemácias dos inúmeros leucócitos e
agora as plaquetas as plaquetas galera que tem uma função primordial no nosso corpo mas primeiro a gente tem que saber que ela Olá seja ela não tem núcleo ela é derivada do médio cariose tu e ela vai ser pequenos fragmentos plaquetas não são praticamente células elas são fragmentos de células esses meio carinhosos vão liberando fragmentos que seriam essas plaquetas EA sua função galera primordial é na coagulação estancar qualquer sangramento também tem uma função de reparo mascular por existir uma lesão do vaso eles estarão lá participando para recuperar essa lesão Então galera com isso temos mais
um resumiu se eu te ajudei de alguma forma se inscreve no canal dê seu joia e não continuar os estudos referente é o estudo do sangue